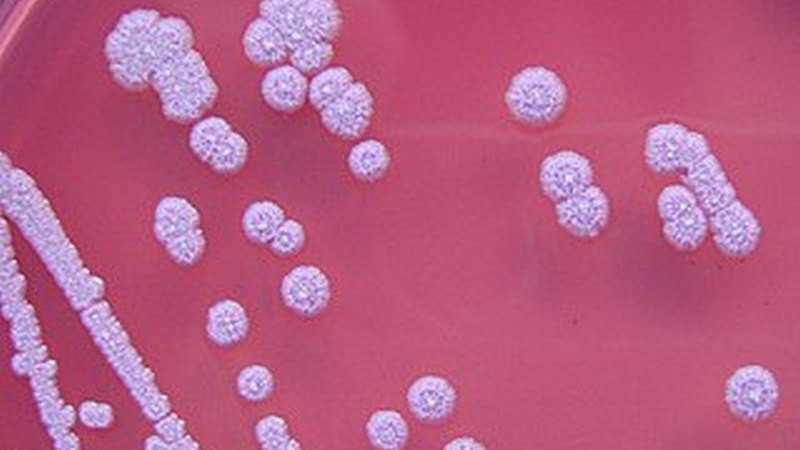
Baja California Sur se encuentra en alerta tras cuatro muertes por melioidosis

La Paz, Baja California Sur, 5 de marzo del 2024.- Autoridades del estado de Baja California Sur llevan a cabo una vigilancia epidemiológica y han comenzado una jornada de toma de muestras para detectar la presencia de la bacteria Burkholderia, la cual causa la enfermedad conocida como melioidosis, que ha provocado la muerte de cuatro personas en la entidad.
La Secretaría de Salud en Baja California Sur informó que con la asistencia técnica de especialistas de la Escuela Nacional de Ciencias Biológicas del Instituto Politécnico Nacional realizó el fin de semana esta jornada en los domicilios de los cinco casos confirmados por este padecimiento y en otros sitios estratégicos.
La titular de la dependencia de salud en Baja California Sur, Zazil Flores Aldape, informó que lo anterior “permitirá fortalecer la implementación de medidas preventivas, entre las que destacan la comunicación de riesgos a la población en general, sobre todo a aquellas personas que tienen mayor vulnerabilidad ante la presencia de la bacteria”.
En tanto se continúa con las labores para prevenir la enfermedad, Flores Aldape exhortó a la población a evitar el contacto con el suelo, agua contaminada o estancada, sobre todo después de la presencia de pocas lluvias.
Las recomendaciones emitidas por el sector salud de la entidad para evitar la enfermedad son uso de botas impermeables durante y después de inundaciones, proteger heridas abiertas, cortes o quemaduras y lavar a fondo cualquier lesión de la piel que entre en contacto con el suelo, evitar beber agua no tratada, incluso evitar alimentos crudos o mal cocidos.